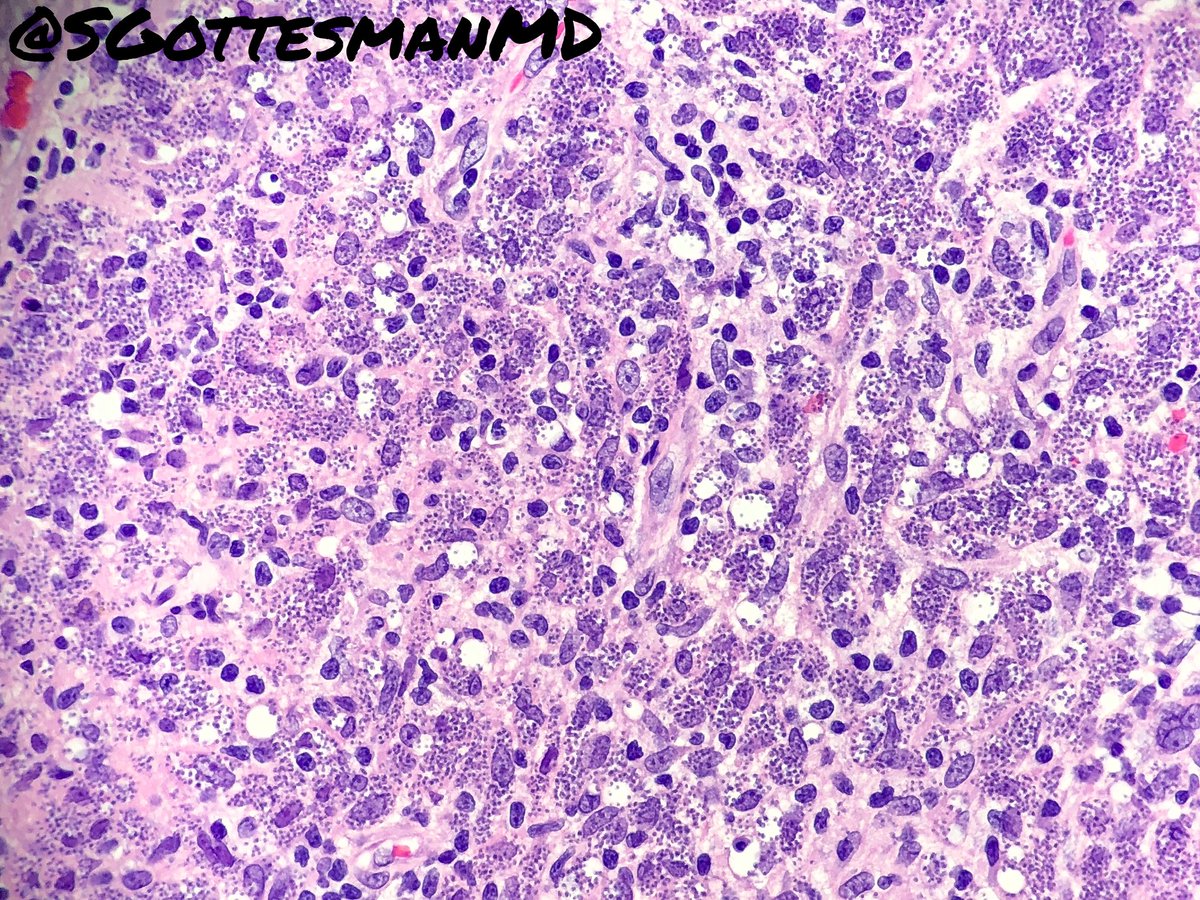
Silvija Gottesman MD tweet media

Grupo Español de Dermatopatología retweetledi

50 yo male, elevated AST/ALT. Beautiful classic histology for...? What’s your ddx? #liverpath

English
Grupo Español de Dermatopatología
90 posts

@GEDP_es
Grupo Español de Dermatopatología #Dermatología #AnatomíaPatológica #dermpath #44reuniónGEDP





























Skin tubercle, consult everybody what disease is this? @histolover @William28538949 @JMGardnerMD